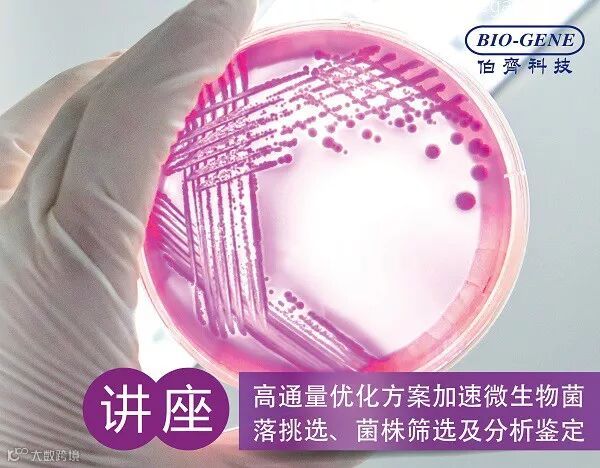

微生物菌种是进行生物制造的核心,其应用领域涉及医药、化工、饲料、能源等多个方面。高通量筛选是获得高性能微生物菌种的重要途径。高通量筛选具有快速、微量、高效、经济的特点。有效控制筛选成本的高通量筛选装备大大促进产学研创新发展和成果转化。本次讲座主要分享围绕微生物菌株筛选与分析的高通量装备。
主要内容
>Hudson RapidPick自动菌落挑选方案
>>M2P微型生物反应器高通量菌株筛选方案
>>>Apogee纳米流式技术快速微生物分析定量方案
>>>> Integra MEDIACLAVE和MEDIAJET培养基制备系统
时间:2019年6月4日 上午 10:00-11:45
地点:深圳先进技术研究院C301会议室
主讲人:刘祖梅 伯齐科技有限公司 技术工程师
推荐阅读:
>MINI TALK:如何加速菌种筛选优化并完美过渡到放大发酵培养
>重磅推荐:Hudson RapidPick自动克隆菌落挑选仪
>Nature Medicine | BMG特色应用-肠道微生物高通量超低氧环境实时培养分析
>Precellys Evolution:微生物组提取无偏差DNA
>讲座视频回放:德国m2p微型生物反应器及对生物制药领域研发的优势
欢迎关注伯齐官方微信(微信公众号:Bio-Gene)
回复:hudson/m2p/apogee,查看相关视频
长按以下二维码可识别关注公众号

伯齐科技有限公司
Bio-Gene Technology Ltd.
广州伯齐生物科技有限公司
热线:176 2009 3784
www.bio-gene.com.cn
marketing@bio-gene.com.cn

